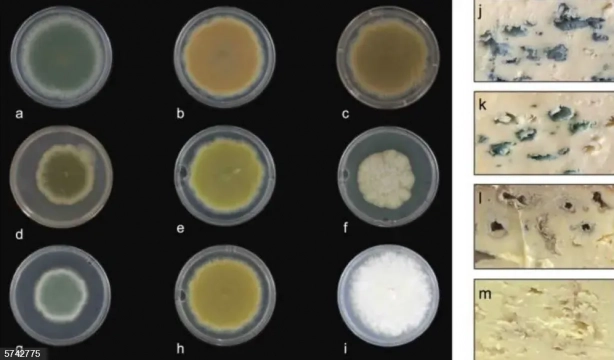
El queso azul podría empezar a producirse concolores y sabores diferentes . Europapress

El queso azul ahora podría ser rojo, verde o rosa
Descubren cómo crearlo en diferentes colores
Expertos de la Facultad de Ciencias de la Vida de la Universidad de Nottingham han descubierto cómo crear queso azul de diferentes colores, a través de una variación del pigmento que crean los hongos de la maduración del queso.
Los hallazgos del estudio se han publicado en la revista Science of Food. Se explica que tras descubrir cómo se crea la clásica veta azul verdosa del queso, el equipo liderado por el Dr. Paul Dyer, profesor de biología fúngica, pudo crear una variedad de cepas de hongos diferentes, que podrían usarse para hacer el queso con colores distintos.
Pueden ir desde el blanco hasta el amarillo verdoso, desde el rojo hasta el rosa pasando por el marrón, o adquirir tonalidades de azules más claras o más oscuras que las que solemos ver habitualmente en el queso.
El hongo del queso
El hongo Penicillium Roqueforti se utiliza en todo el mundo para la producción de quesos de veta azul como el Stilton, Roquefort y Gorgonzola. Su color y sabor únicos, azul verdoso, provienen de esporas pigmentadas formadas por el crecimiento de hongos.
Combinando la bioinformática junto con deleciones genéticas específicas y genes heterólogos, este equipo de investigación aprendió la manera en la que se produce el pigmento azul verdoso tradicional.
Después, utilizando algunas técnicas clásicas seguras para los alimentos (no transgénicas) pudieron "bloquear" el camino en ciertos puntos y así crear cepas con nuevos colores que pueden usarse en la producción.
El Dr. Dyer dijo: "Hemos estado interesados en los hongos del queso durante más de 10 años y tradicionalmente, cuando se desarrollan quesos madurados con moho, se obtienen quesos azules como Stilton, Roquefort y Gorgonzola, que utilizan cepas fijas de hongos que son de color azul verdoso."
Nuevos colores y sabores diferentes del queso
Como querían averiguar si se podían desarrollar nuevas cepas, con nuevos sabores y apariencias, indujeron la reproducción sexual en el hongo. Generaron una amplia gama de cepas con sabores diferentes y novedosos, tanto suaves como intensos y luego crearon nuevas versiones de colores.
Una vez que el equipo produjo el queso con las nuevas cepas de color, utilizaron instrumentos de diagnóstico de laboratorio para ver cómo sería el sabor. "Descubrimos que el sabor era muy similar al de las cepas azules originales de las que se derivaron".
Según Dyer. "Hubo diferencias sutiles pero no muchas. Lo interesante fue que una vez que hicimos algo de queso, hicimos algunas pruebas de sabor con voluntarios de toda la Universidad y descubrimos que cuando las personas probaban las variedades de colores más claros pensaban que sabían más suaves. Pensaron que la cepa más oscura tenía un sabor más intenso".

Matt Cleere, un estudiante de posgrado que ha participado en el equipo, trabajará con queseros de varias partes de Reino Unido y Escocia para crear las nuevas variantes de color del queso azul. También se ha creado una empresa derivada de la Universidad llamada Myconeos para ver si las cepas se pueden comercializar.
"Personalmente, creo que brindará a la gente una sensación sensorial realmente satisfactoria al comer estos nuevos quesos y, con suerte, podría atraer a algunas personas nuevas al mercado", añade el Dr. Dyer.